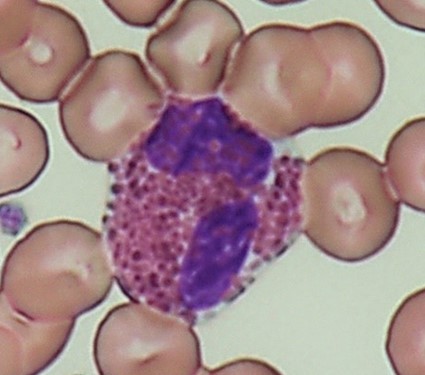
写真　好酸球

血液検査室
概要
血液は全身の健康状態が反映されます。血液検査をすることで体の異常をある程度把握することができます。血液検査室では、患者様から採取された検体をもとに血球算定(血球数)や血液像(白血球分類)、血液凝固検査、骨髄検査などを行います。貧血や出血傾向、炎症の程度または白血病などの血液疾患の診断や治療効果の判定に役立てられます。
血球算定と白血球分類
赤血球、白血球、血小板は主に骨髄で作られ、血球成分は血管を通って全身に流れています。それぞれの血球成分は構造も機能も大きく異なり様々な性質を持っていますが、起源となる細胞は同じものと考えられています。この細胞を造血幹細胞と呼びます。血液検査室では各血球成分の数(血球算定)や白血球の分類を行います。
①血球算定
- 赤血球数・ヘマトクリット値・ヘモグロビン量
貧血の原因や種類を知ることができます。 - 白血球数
感染症・炎症の有無、治療効果・予後の判定などを目的とします。 - 血小板数
出血傾向の有無や血栓症の危険性、治療状態などを知ることができ、疾患により凝固検査の結果と併せて判断されます。

血球にはどんな働きがあるの?
| 役割 | |
| 赤血球 | 酸素の運搬を行います。赤血球の中はヘモグロビンが密に詰まっていて、このヘモグロビンと酸素が結合して体内の組織へ運ばれます。血球は、体の隅々まで酸素を運ぶため、血管の中へ入っていきます.その時、様々な形に変えて流れていくので円盤状の形をしています。 |
| 白血球 | 生体を防御する機能を持っています。けがをして細菌が体の中へ侵入すると、細菌を攻撃し破壊します。その細菌を自分の中に取り込むことでこの役割をはたします。白血球は、防御作用のためにさまざまな構造や機能を持ったものが見られます。 |
| 血小板 | 血液の止血に大きな役割を果たします。血管が傷つき出血すると、偽足状の突起を出して出血した部位に集まり凝集し始めます。さらに、血漿中のフィブリノーゲンが繊維状のフィブリンに変化し、このフィブリンが絡みついて凝集をより強くして血液を固めます。 |
②末梢血液像
血液中に流れる白血球には、好中球・好酸球・好塩基球・リンパ球・単球の5種類があります。機械と顕微鏡を併用し、それぞれの割合(%)や異常な白血球の有無等を調べることで、様々な病態を把握します。
白血球にはどんな種類があるの?
| 細胞像 | 機能 | |
| 好中球 | ![]() |
運運動走化能・貪食能・殺菌能を有し、細菌などの体内異物の処理を行います。 |
| リンパ球 | |
免疫反応の中核を担う細胞です。 |
| 単球 | ![]() |
マクロファージへの分化、殺菌、抗原提示、抗腫瘍作用、顆粒球及び単球の産生刺激などの機能を持ちます。 |
| 好酸球 | ![]() |
特有の機能として寄生虫の殺傷作用のほか、アレルギー性疾患(気管支喘息など)における組織障害という生体にマイナスの作用をもたらすこともあります。 |
| 好塩基球 | ![]() |
特有の機能としてヒスタミンの放出によるアナフィラキシーショック、じんましん、気管支喘息などのアレルギー反応、好酸球をひきつける走化因子を出すなどの機能を持ちます。 |
凝固検査
血液は血栓形成作用と抗血栓形成作用の相反する二つの作用を持ちバランスを保っています。血管が損傷してダメージを受けると、止血するために血栓をつくります。体内では必要以上に血液凝固が進行しないようにする機序や血栓を分解する機序(線溶)が働き、円滑な血流を保とうとします。どちらかのバランスが崩れ、血栓形成作用が強く働くと血栓傾向が生じ、抗血栓傾向が強く働くと出血傾向が出現します。
凝固検査の項目としては、APTT(活性化部分トロンボプラスチン時間)、PT(プロトロンビン時間)、FBG(フィブリノーゲン)、ATⅢ(アンチトロンビンⅢ)、HPT(ヘパプラスチン)、TT(トロンボテスト)、DD(Dダイマー)、FDP(フィブリン・フィブリノーゲン分解産物)があります。
骨髄検査
末梢血液検査の結果によっては腸骨あるいは胸骨から骨髄液を採取し、骨髄の造血機能を形態的に調べます。血液疾患などの診断や治療効果、化学療法の効果の判定に有用です。
フローサイトメトリー検査
末梢血、骨髄液、体腔液などに含まれる細胞をひとつひとつ解析して、各細胞の種類やどれくらいの割合で存在するのかを調べる検査です。この検査は血球細胞の種類や成熟段階を知る手掛かりを与えてくれるため、白血病やリンパ腫の病型診断や治療効果判定などに使われています。